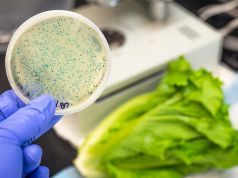
Got This Lettuce in Your Fridge? Throw it Out Before You Get Sick

8 Ways to Enjoy an Alternative Christmas This Year
Has the same old holiday routine put you in a funk this year? Are you tired of the same food, the same activities, and...
What You Might Not Know About Fiber Supplements Could Hurt You
Eating a high fiber diet has many advantages, including keeping your gut healthy and happy, boosting heart health, gut health, and improving weight loss...
Caution: Eating Raw Cookie Dough Can Send You to the ER
Ah, the holidays, the best time for year for joy, friendship, family, laughter, and...E. Coli? With Thanksgiving leftovers still in the fridge and the...
16 Ways to Use This Miracle Spice From the Bible as a Natural Remedy
Nigella sativa is an herb native to Southwestern Asia, the Mediterranean, and North Africa with extraordinary therapeutic value. Evidence of its use dates back...
7 Reasons Your Lips are Tingling (#3 will surprise you)
It can be uncomfortable and frustrating when it happens, but could it also be more than a nuisance - perhaps a sign of a...
Got This Lettuce in Your Fridge? Throw it Out Before You Get Sick
Here we are again, reeling in the wake of another Romaine lettuce recall days before Thanksgiving. Like last year, this recall is related to...
7 Ways to End Your Leaky Bladder for Good
If you are a woman and you’ve peed your pants after sneezing, take heart...you are not alone. Many women experience this common and sometimes...
9 Science-Backed Reasons to Eat Turmeric Daily
You can’t miss the beautiful and vibrant color of turmeric (Curcuma longa) and its comforting aroma that fills your senses. This ancient herbaceous spice...
Smoking Weed vs. Smoking Tobacco: What Science Says
State legalization of weed is sweeping the nation in full force as the debate regarding support of this federally classed schedule 1 drug persists....
Do These 9 Things to End Morning Joint Pain
How many mornings do you wake up and feel like you have been run over by a truck in your sleep? Joint stiffness and...